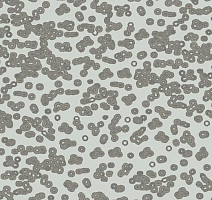
Ковролин Flotex Sottsass Bacteria 990201 фото 1 | FLOORDEALER

Популярное
Бренд
Цвет
Тип
Назначение
Ширина
Класс
Основа
Тип ворса
Состав ворса
Сбросить
Найдено: 1062 товара
Сортировка
Флокированный
Очистить все
Flotex Linear Stratus s 242003 / t 540003 sisal
Код товара
241607
Flotex Linear Cirrus s 270001 / t 570001 sulphur
Код товара
241610
Flotex Linear Cirrus s 270003 / t 570003 sisal
Код товара
241612
Flotex Sottsass Terrazzo 990704
Код товара
241616
Flotex Sottsass Terrazzo 990702
Код товара
241617
Flotex Sottsass Kasuri 990801
Код товара
241618
Flotex Sottsass Kasuri 990803
Код товара
241619
Flotex Sottsass Kasuri 990807
Код товара
241620
Flotex Sottsass Bacteria 990105
Код товара
241623
Flotex Vision Image 000369 Grass
Код товара
241637
Flotex Vision lines 710001 (Chevron) Shore
Код товара
241638
Flotex Linear Stratus s 242011 / t 540011 leather
Код товара
241647
Flotex Linear Stratus s 242012 / t 540012 walnut
Код товара
241648
Flotex Linear Stratus s 242014 / t 540014 eclipse
Код товара
241649
Flotex Linear Stratus s 242007 / t 540007 mint
Код товара
241650
Flotex Linear Stratus s 242008 / t 540008 onyx
Код товара
241651
Flotex Linear Cirrus s 270006 / t 570006 ruby
Код товара
241652
Flotex Linear Cirrus s 270015 / t 570015 storm
Код товара
241653
Flotex Linear Cirrus s 270014 / t 570014 eclipse
Код товара
241654
Flotex Linear Cirrus s 270008 / t 570008 onyx
Код товара
241655
Flotex Linear Cirrus s 270005 / t 570005 sapphire
Код товара
241656
Flotex Sottsass Terrazzo 990703
Код товара
241657
Flotex Sottsass Terrazzo 990713
Код товара
241659
Flotex Sottsass Terrazzo 990711
Код товара
241660
Flotex Vision Image 000428 illusion
Код товара
241685
Flotex Vision lines 710006 (Chevron) Storm
Код товара
241687
Flotex Vision lines 520002 (Cord) Sky
Код товара
241688
Flotex Vision lines 520003 (Cord) Tropicana
Код товара
241689
Flotex Vision lines 520004 (Cord) Grape
Код товара
241690
Flotex Linear Stratus s 242015 / t 540015 storm
Код товара
241700
Flotex Sottsass Terrazzo 990709
Код товара
241702
Flotex Sottsass Terrazzo 990710
Код товара
241703
Flotex Sottsass Terrazzo 990706
Код товара
241704
Flotex Sottsass Kasuri 990816
Код товара
241706
Flotex Sottsass Kasuri 990805
Код товара
241707
Flotex Sottsass Kasuri 990806
Код товара
241708
Flotex Sottsass Kasuri 990813
Код товара
241709
Flotex Sottsass Kasuri 990814
Код товара
241710
Flotex Sottsass Bacteria 990402
Код товара
241711
Flotex Sottsass Bacteria 990403
Код товара
241712
Flotex Sottsass Bacteria 990203
Код товара
241713
Flotex Sottsass Bacteria 990202
Код товара
241714
Flotex Sottsass Bacteria 990201
Код товара
241715
Flotex Vision Floral 670005 (Floret) Iris
Код товара
241717
Flotex Vision Floral 670006 (Floret) Cyclamen
Код товара
241718
Flotex Vision Floral 670003 (Floret) Orchid
Код товара
241719
Flotex Vision Floral 670004 (Floret) Poppy
Код товара
241720
Flotex Vision Floral 640004 (Autumn) Mineral
Код товара
241721
Flotex Vision Image 000430 Shamrock
Код товара
241722
Flotex Vision Image 000450 Woodchip
Код товара
241724
Flotex Vision Image 000509 Autumn Leaves Green
Код товара
241725
Flotex Vision Image 000510 Pebbles
Код товара
241726
Flotex Vision lines 520005 (Cord) Cement
Код товара
241727
Flotex Vision lines 520001 (Cord) Candy
Код товара
241728
Flotex Vision lines 520006 (Cord) Tide
Код товара
241729
Flotex Vision lines 520007 (Cord) Ginger
Код товара
241730
Flotex Vision lines 520020 (Cord) Berry
Код товара
241794
 Бежевый
Бежевый  Серый
Серый  Коричневый
Коричневый  Белый
Белый  Черный
Черный  Зеленый
Зеленый  Красный
Красный  Синий
Синий  Разноцветный
Разноцветный  Бирюзовый
Бирюзовый  Бордовый
Бордовый  Голубой
Голубой  Графит
Графит  Желтый
Желтый  Оранжевый
Оранжевый  Песочный
Песочный  Розовый
Розовый  Салатовый
Салатовый  Сиреневый
Сиреневый  Фиолетовый
Фиолетовый  Черно-белый
Черно-белый 



 Дуб
Дуб  Рыжий
Рыжий  Темно-серый
Темно-серый  Натуральный
Натуральный  Золотой
Золотой  Светлый
Светлый  Темный
Темный  Темно-синий
Темно-синий  Бронза
Бронза  Медь
Медь  Орех
Орех  Ясень
Ясень  Бук
Бук  Венге
Венге  Вишня
Вишня  Груша
Груша  Каштан
Каштан  Махагон
Махагон  Мербау
Мербау  Серебро
Серебро  Сосна
Сосна 


























.jpg)